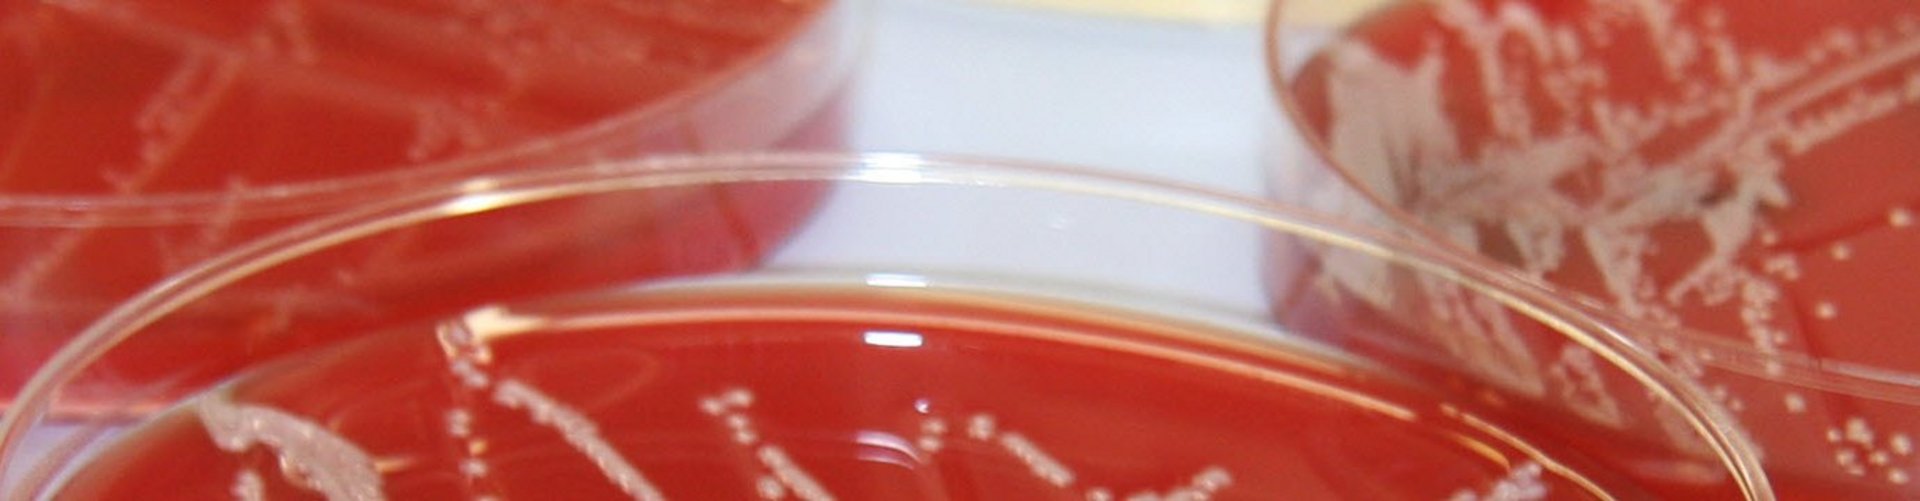
Landeskontrollverband Berlin-Brandenburg eV Landeskontrollverband Berlin-Brandenburg eV

Formularcenter
Formulare für alle Bereiche
GeRo / MLP
Gesundheit u. Robustheit (GeRo), Milchleistungs- und Qualitätsprüfung (MLP)
 © shutterstock / Parilov
© shutterstock / ParilovMilchgüte
Rohmilchqualität, Mindestuntersuchungsdichte, Untersuchungsverfahren
Mastitis
mikrobiologische Mastitisdiagnostik
Tierkennzeichnung
Registrierung, Kennzeichnung, HIT
Futter
Untersuchung auf wertgebende und wertmindernde Inhaltsstoffe (Silagen, Mischfuttermittel)
Boden
Boden und komplexe Pflanzenanalyse
Biogas und org. DS
Wirtschaftsdünger, nachwachsende Rohstoffe und Fermenterinhalte